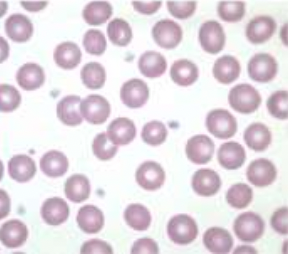
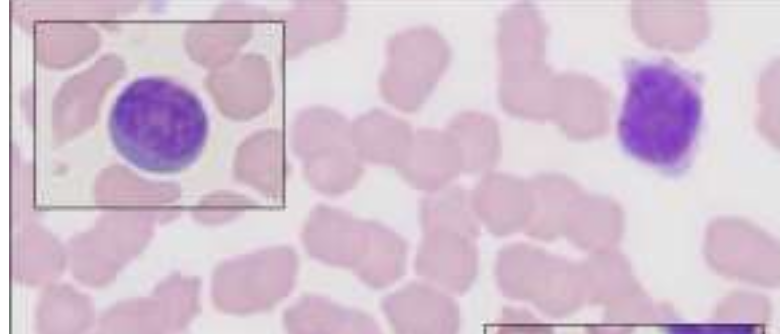
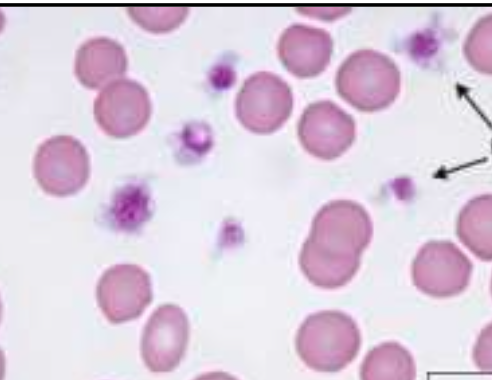
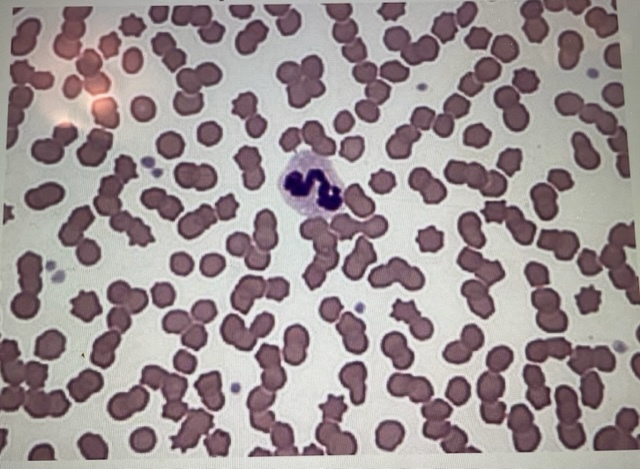
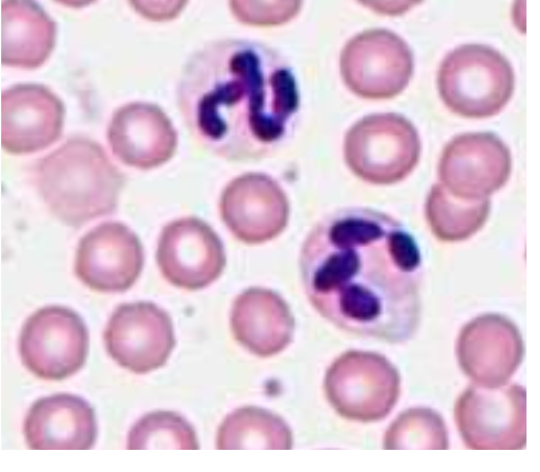
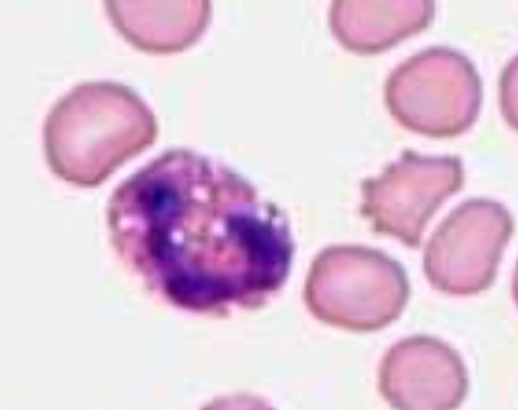
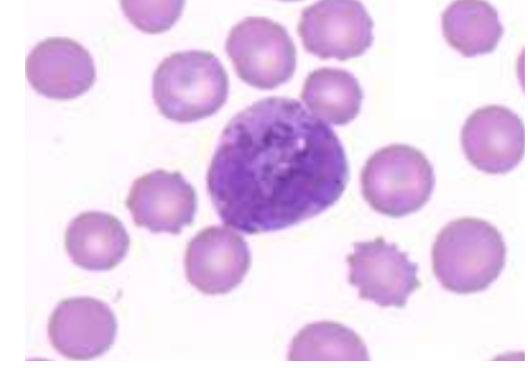

1
Q
A
red blood cells (errythrocytes)
High: erythrocytosis
Low: anemia/erythrocytopenia
2
Q

A
neutrophils
high: neutrophilia
low: neutropenia
3
Q

A
eosinophils
high: eosinophila
low: eosinopenia
4
Q

A
basophils
high: basophilia
low: basopenia
5
Q

A
monocytes
high: monocytosis
low: monocytopenia
6
Q
A
lymphocytes
high: lymphocytois
low: lymphocytopenia
7
Q
A
platelets
high: thrombocytosis
low: thrombocytopenia
8
Q
A
neutrophil
9
Q
A
neutrophil
10
Q
A
eosinophil
11
Q
A
basophil


